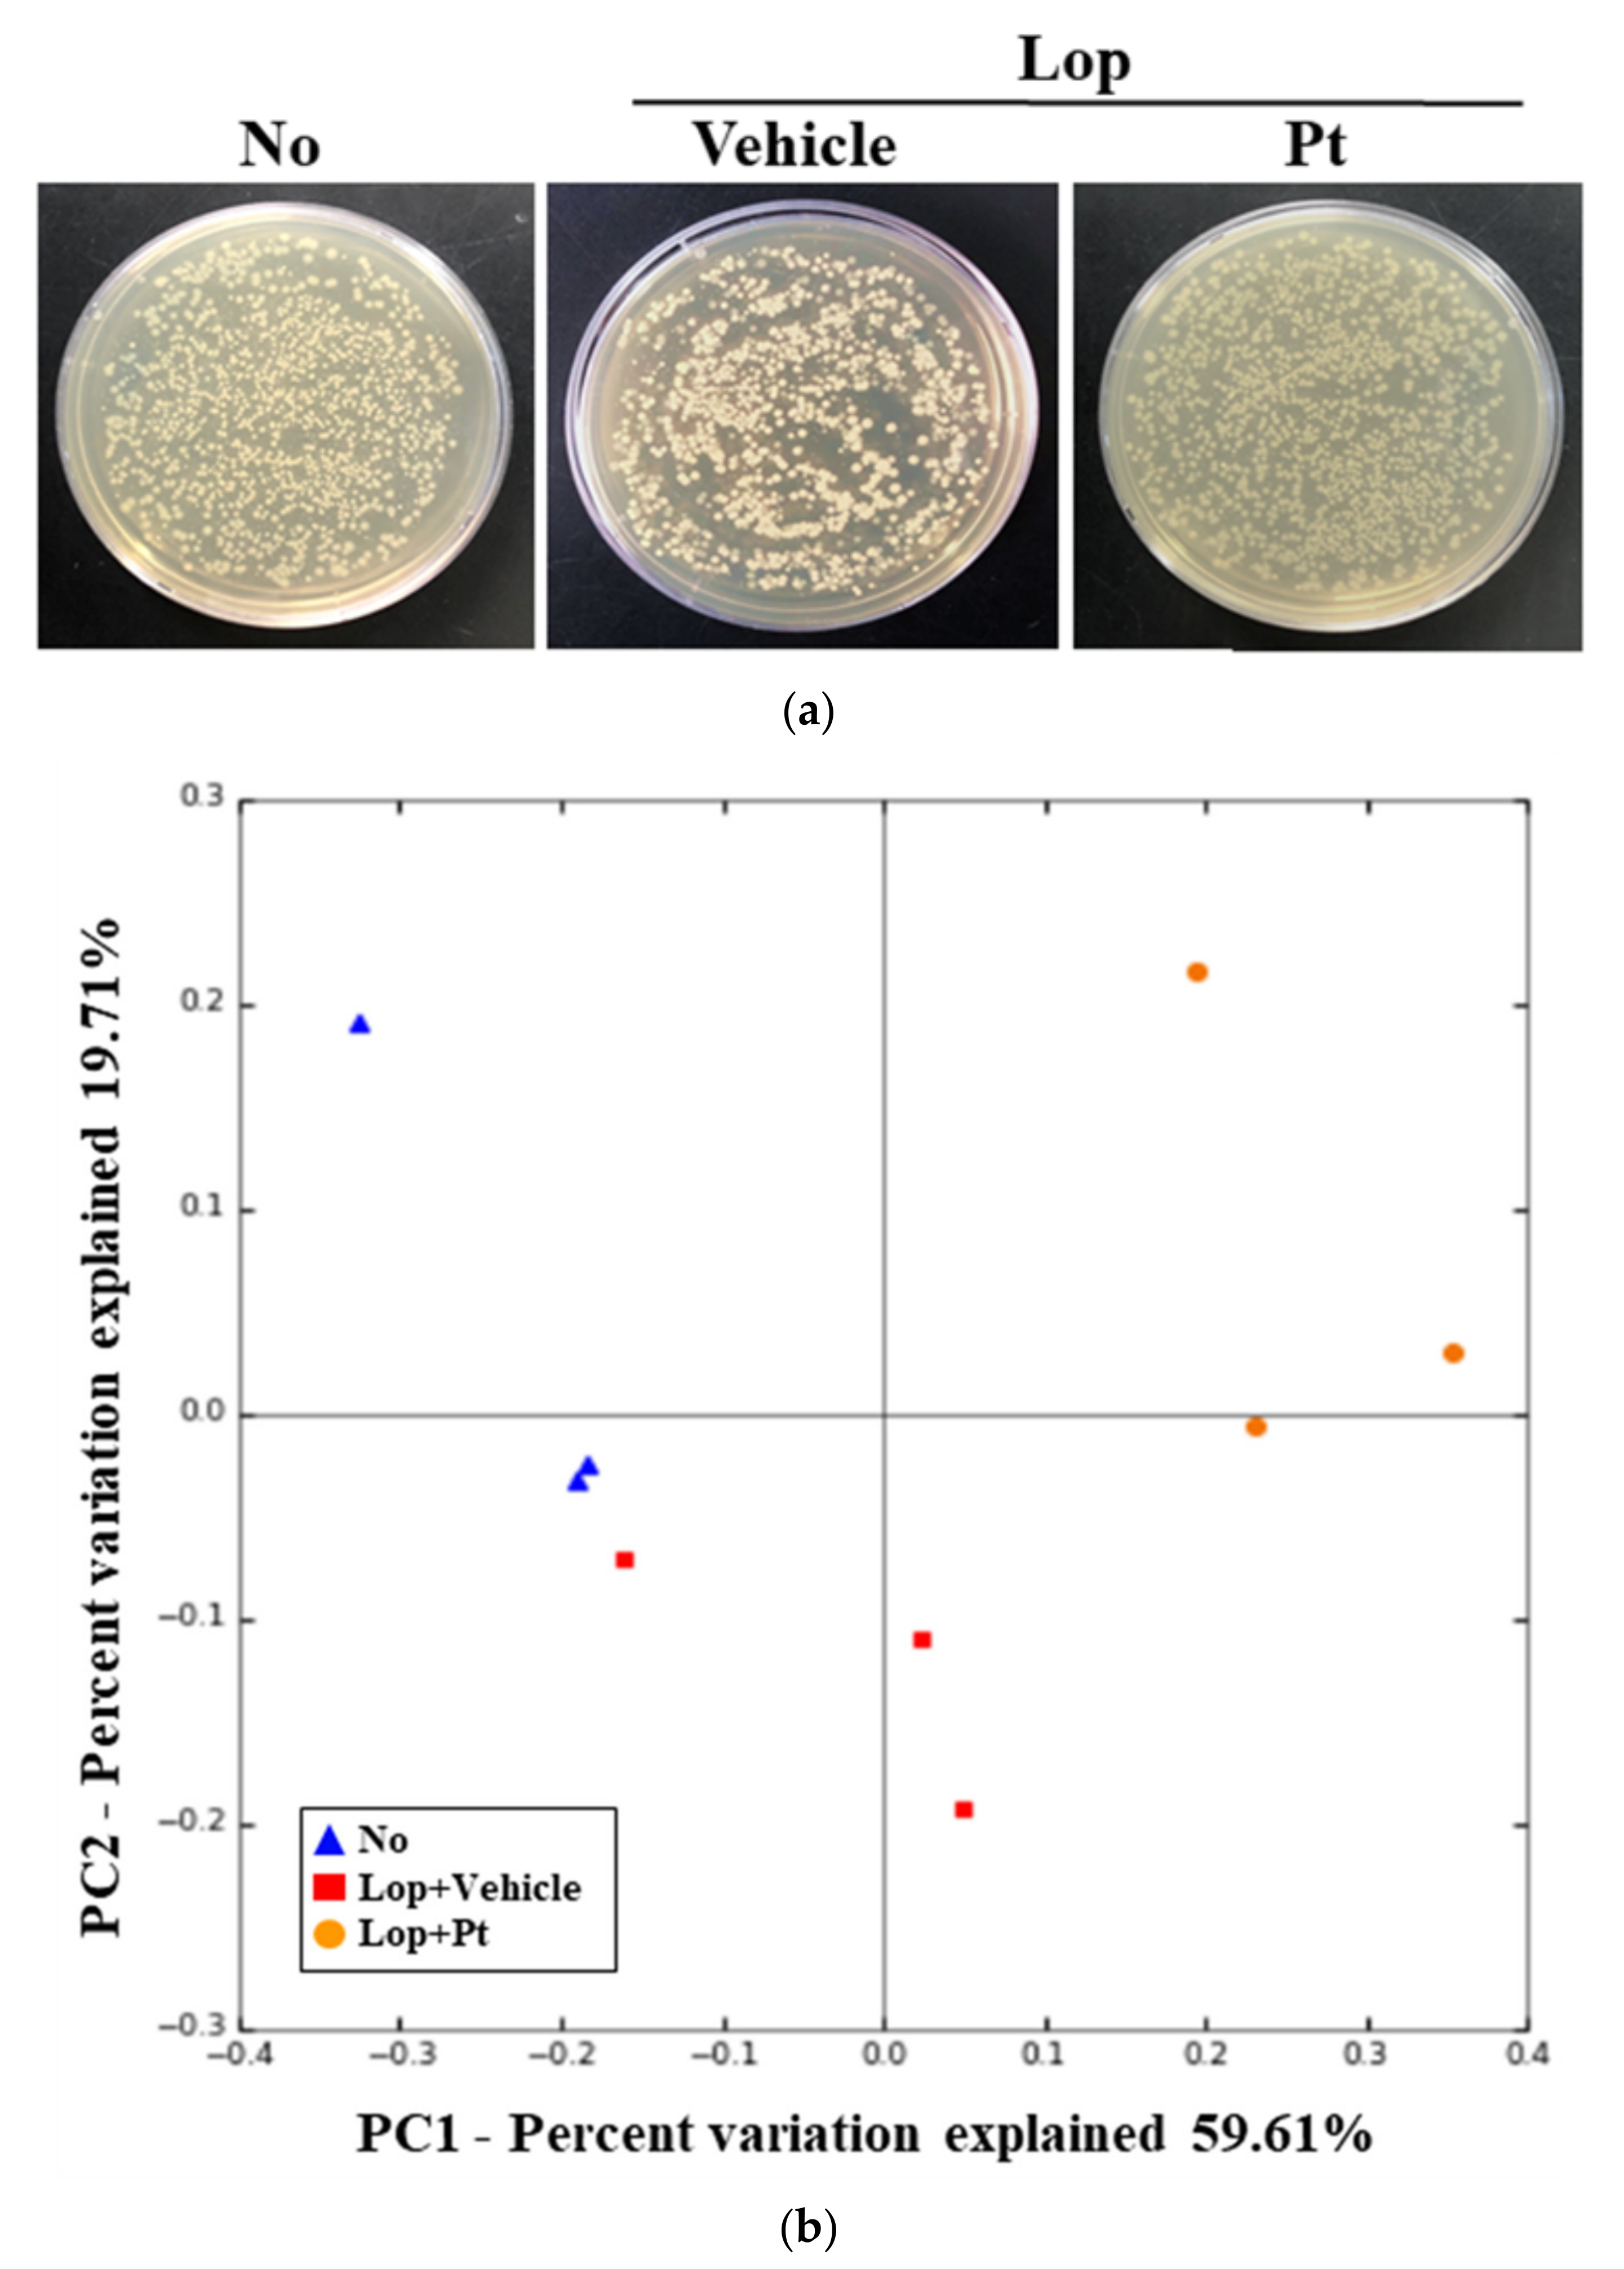
Molecules 26 07209 g007 550

Laxative Effects of Phlorotannins Derived from Ecklonia cava on Loperamide-Induced Constipation in SD Rats
Abstract
:1. Introduction
2. Results
2.1. Confirmation of Pt Purified from E. cava
2.2. Effect of Pt Administration on Feeding Behavior and Excretion Parameters
2.3. Effect of Pt Administration on GI Motility and Intestinal Length
2.4. Effect of Pt Administration on Histopathological and Cytological Structure of the Mid-Colon
2.5. Effect of Pt Administration on Regulatory Function of Mucin and Water
2.6. Effect of Pt Administration on Regulation of GI Hormone Secretions
2.7. Effect of Pt Administration on the Downstream Signaling Pathway of mAChRs
2.8. Effect of Pt Administration on the Profile of Fecal Microbiota
3. Discussion
4. Materials and Methods
4.1. Preparation of Pt from E. cava
4.2. Liquid Chromatography–Mass Spectrometry (LC–MS) Analysis
4.3. Experimental Design for Animal Study
4.4. Measurement of Food Intake and Water Consumption
4.5. Measurement of Stool Parameters and Urine Volume
4.6. Measurement of Gastrointestinal Transit Ratio and Intestinal Length
4.7. Western Blotting Analysis
4.8. Quantitative Real-Time Polymerase Chain Reaction (qRT-PCR) Analysis
4.9. Histopathological Analysis
4.10. Transmission Electron Microscopy (TEM) Analysis
4.11. Determination of GI Hormone Concentrations
4.12. Analysis of Fecal Microbiota
4.13. Statistical Analysis
5. Conclusions
Author Contributions
Funding
Institutional Review Board Statement
Informed Consent Statement
Data Availability Statement
Acknowledgments
Conflicts of Interest
Sample Availability
References
- Jang, S.K.; Lee, D.I.; Kim, S.T.; Kim, G.H.; Park, D.W.; Park, J.Y.; Han, D.; Choi, J.K.; Lee, Y.; Han, N.S.; et al. The anti-aging properties of a human placental hydrolysate combined with dieckol isolated from Ecklonia cava. BMC Complement. Altern. Med. 2015, 15, 345. [Google Scholar] [CrossRef] [Green Version]
- Ahn, G.N.; Kim, K.N.; Cha, S.H.; Song, C.B.; Lee, J.H.; Heo, M.S.; Yeo, I.K.; Lee, N.H.; Jee, Y.H.; Kim, J.S. Antioxidant activities of phlorotannins purified from Ecklonia cava on free radical scavenging using ESR and H2O2-mediated DNA damage. Eur. Food Res. Technol. 2007, 226, 71–79. [Google Scholar] [CrossRef]
- Kang, S.M.; Kim, K.N.; Lee, S.H.; Ahn, G.; Cha, S.H.; Kim, A.D.; Yang, X.D.; Kang, M.C.; Jeon, Y.J. Anti-inflammatory activity of polysaccharide purified from AMG-assistant extract of Ecklonia cava in LPS-stimulated RAW264.7 macrophages. Carbohydr. Polym. 2011, 85, 80–85. [Google Scholar] [CrossRef]
- Lee, H.K.; Kang, C.K.; Jung, E.S.; Kim, J.S.; Kim, E.K. Antimetastatic activity of polyphenol-rich extract of Ecklonia cava through the inhibition of Akt pathway in A549 human lung cancer cells. Food Chem. 2011, 127, 1229–1236. [Google Scholar] [CrossRef] [PubMed]
- Kang, S.M.; Cha, S.H.; Ko, J.Y.; Kang, M.C.; Kim, D.K.; Heo, S.J.; Kim, J.S.; Heu, M.S.; Kim, Y.T.; Jung, W.K.; et al. Neuroprotective effects of phlorotannins isolated from a brown alga, Ecklonia cava, against H2O2-induced oxidative stress in murine hippocampal HT22 cells. Environ. Toxicol. Pharmacol. 2012, 34, 96–105. [Google Scholar] [CrossRef]
- Fukuyama, Y.; Kodama, M.; Miura, I.; Kinzyo, Z.; Kido, M.; Mori, H.; Nakayama, Y.; Takahashi, M. Structure of an anti-plasmin inhibitor, eckol, isolated from the brown alga Ecklonia kurome Okamura and inhibitory activities of its derivatives on plasma plasmin inhibitors. Chem. Pharm. Bull. 1989, 37, 349–353. [Google Scholar] [CrossRef] [Green Version]
- Heo, S.J.; Ko, S.C.; Cha, S.H.; Kang, D.H.; Park, H.S.; Choi, Y.U.; Kim, D.; Jung, W.K.; Jeon, Y.J. Effect of phlorotannins isolated from Ecklonia cava on melanogenesis and their protective effect against photo-oxidative stress induced by UV-B radiation. Toxicol. In Vitro 2009, 23, 1123–1130. [Google Scholar] [CrossRef]
- Yoo, C.Y.; Kim, S.Y.; Park, J.W.; Sung, S.A.; Kim, D.A.; Park, J.H.; Xuan, A.H.; Park, S.N. Antioxidant and cellular protective activities of Ecklonia cava extracts against reactive oxygen species. J. Soc. Cosmet. Sci. Korea 2015, 41, 287–294. [Google Scholar]
- Heo, S.J.; Park, E.U.; Lee, K.W.; Jeon, Y.J. Antioxidant activities of enzymatic extracts from brown seaweeds. Biores. Technol. 2005, 96, 1613–1623. [Google Scholar] [CrossRef]
- Kang, K.A.; Lee, K.H.; Chae, S.; Zhang, R.; Jung, M.S.; Lee, Y.; Kim, S.Y.; Kim, H.S.; Joo, H.G.; Park, J.W.; et al. Eckol isolated from Ecklonia cava attenuates oxidative stress induced cell damage in lung fibroblast cells. FEBS Lett. 2005, 579, 6295–6304. [Google Scholar] [CrossRef] [Green Version]
- Kumari, M.; Jain, S. Tannins: An antinutrient with positive effect to manage diabetes. Res. J. Recent Sci. 2012, 1, 1–8. [Google Scholar]
- Hwang, D.Y. Therapeutic Role of Natural Products Containing Tannin for Treatment of Constipation, 1st ed.; Mozsik, G., Ed.; IntechOpen: London, UK, 2018; pp. 1–19. [Google Scholar]
- Liu, H.; Gu, L. Phlorotannins from brown algae (Fucus vesiculosus) inhibited the formation of advanced glycation endproducts by scavenging reactive carbonyls. J. Agric. Food Chem. 2012, 60, 1326–1334. [Google Scholar] [CrossRef] [PubMed]
- Li, Y.; Fu, X.; Duan, D.; Liu, X.; Xu, J.; Gao, X. Extraction and identification of phlorotannins from the brown alga, Sargassum fusiforme (Harvey) Setchell. Mar. Drugs 2017, 15, 49. [Google Scholar] [CrossRef] [PubMed] [Green Version]
- Liu, X.; Yuan, W.; Sharma-Shivappa, R.; van Zanten, J. Antioxidant activity of phlorotannins from brown algae. Setchell. Mar. Drugs 2017, 15, 49. [Google Scholar] [CrossRef]
- Yotsu-Yamashita, M.; Kondo, S.; Segawa, S.; Lin, Y.C.; Toyohara, H.; Ito, H.; Konoki, K.; Cho, Y.; Uchida, T. Isolation and structural determination of two novel phlorotannins from the brown alga Ecklonia kurome Okamura, and their radical scavenging activities. Mar. Drugs 2013, 11, 165–183. [Google Scholar] [CrossRef] [PubMed] [Green Version]
- Tierney, M.S.; Soler-Vila, A.; Rai, D.K.; Croft, A.K.; Brunton, N.P.; Smyth, T.J. UPLC-MS profiling of low molecular weight phlorotannin polymers in Ascophyllum nodosum, Pelvetia canaliculata and Fucus spiralis. Metabolomics 2013, 10, 524–535. [Google Scholar] [CrossRef]
- Li, Y.; Qian, Z.J.; Ryu, B.M.; Lee, S.H.; Kim, M.M.; Kim, S.K. Chemical components and its antioxidant properties in vitro: An edible marine brown alga, Ecklonia cava. Bioorg. Med. Chem. 2009, 17, 1963–1973. [Google Scholar] [CrossRef] [PubMed]
- Artan, M.; Li, Y.; Karadeniz, F.; Lee, S.H.; Kim, M.M.; Kim, S.K. Anti-HIV-1 activity of phloroglucinol derivative, 6,60 -bieckol, from Ecklonia cava. Bioorg. Med. Chem. 2008, 16, 7921–7926. [Google Scholar] [CrossRef] [PubMed]
- Jung, W.K.; Ahn, Y.W.; Lee, S.H.; Choi, Y.H.; Kim, S.K.; Yea, S.S.; Choi, I.; Park, S.G.; Seo, S.K.; Lee, S.W.; et al. Ecklonia cava ethanolic extracts inhibit lipopolysaccharide-induced cyclooxygenase-2 and inducible nitric oxide synthase expression in BV2 microglia via the MAP kinase and NF-kB pathways. Food Chem. Toxicol. 2009, 47, 410–417. [Google Scholar] [CrossRef]
- Zhang, R.; Kang, K.A.; Piao, M.J.; Ko, D.O.; Wang, Z.H.; Lee, I.K.; Kim, B.J.; Jeong, I.Y.; Shin, T.; Park, J.W.; et al. Eckol protects V79–4 lung fibroblast cells against t-ray radiation-induced apoptosis via the scavenging of reactive oxygen species and inhibiting of the c-Jun NH2-terminal kinase pathway. Eur. J. Pharmacol. 2008, 591, 114–123. [Google Scholar] [CrossRef]
- Lee, S.H.; Li, Y.; Karadeniz, F.; Kim, M.M.; Kim, S.K. a–Glycosidase and a–amylase inhibitory activities of phloroglucinal derivatives from edible marine brown alga, Ecklonia cava. J. Sci. Food Agric. 2009, 89, 1552–1558. [Google Scholar] [CrossRef]
- Kong, C.S.; Kim, J.A.; Yoon, N.Y.; Kim, S.K. Induction of apoptosis by phloroglucinol derivative from Ecklonia cava in MCF-7 human breast cancer cells. Food Chem. Toxicol. 2009, 47, 1653–1658. [Google Scholar] [CrossRef]
- Wintola, O.A.; Sunmonu, T.O.; Afolayan, A.J. The effect of Aloe ferox Mill. in the treatment of loperamide-induced constipation in Wistar rats. BMC Gastroenterol. 2010, 10, 95. [Google Scholar] [CrossRef] [Green Version]
- Ugwah-Oguejiofor, C.J.; Bello, S.O.; Etuk, E.U.; Igbokwe, V.U.; Ugwah, O.M.; Okolo, R.U. Preliminary toxicity and phytochemical studies of the aqueous extract of Ficus platyphylla in female albino rats. J. Pharm. Pharmacol. 2020, 9, 1–7. [Google Scholar]
- Kim, J.E.; Lee, Y.J.; Kwak, M.H.; Ko, J.; Hong, J.T.; Hwang, D.Y. Aqueous extracts of Liriope platyphylla induced significant laxative effects on loperamide-induced constipation of SD rats. BMC Complement. Altern. Med. 2013, 13, 333. [Google Scholar] [CrossRef] [PubMed] [Green Version]
- Kim, J.E.; Choi, Y.J.; Lee, S.J.; Gong, J.E.; Lee, Y.J.; Sung, J.E.; Jung, Y.S.; Lee, H.S.; Hong, J.T.; Hwang, D.Y. Antioxidant activity and laxative effects of tannin-enriched extract of Ecklonia cava in loperamide-induced constipation of SD rats. PLoS ONE 2021, 16, e0246363. [Google Scholar] [CrossRef] [PubMed]
- Choi, H.S.; Jeon, H.J.; Lee, O.H.; Lee, B.Y. Dieckol, a major phlorotannin in Ecklonia cava, suppresses lipid accumulation in the adipocytes of high-fat diet-fed zebrafish and mice: Inhibition of early adipogenesis via cell-cycle arrest and AMPKα activation. Mol. Nutr. Food Res. 2015, 59, 1458–1471. [Google Scholar] [CrossRef]
- Na, J.R.; Oh, K.N.; Park, S.U.; Bae, D.; Choi, E.J.; Jung, M.A.; Choi, C.Y.; Lee, D.W.; Jun, W.; Lee, K.Y.; et al. The laxative effects of Maesil (Prunus mume Siebold & Zucc.) on constipation induced by a low-fiber diet in a rat model. Int. J. Food Sci. Nutr. 2013, 64, 333–345. [Google Scholar]
- Sabiu, S.; Ashafa, O.T. Toxicological implications and laxative potential of ethanol root extract of Morella serrata in loperamide-induced constipated Wistar rats. Pharm. Biol. 2016, 54, 2901–2908. [Google Scholar] [CrossRef] [PubMed]
- Kim, J.E.; Go, J.; Koh, E.K.; Song, S.H.; Sung, J.E.; Lee, H.A.; Lee, Y.H.; Hong, J.T.; Hwang, D.Y. Gallotannin-enriched extract isolated from Galla Rhois may be a functional candidate with laxative effects for treatment of loperamide-induced constipation of SD rats. PLoS ONE 2016, 11, e0161144. [Google Scholar] [CrossRef]
- Change, K.J.; Xu, Z.; You, J.S.; Huan, D.; Lee, C.M. Effect of dietary supplementation with Laminaria japonica and Laminaria saccharina on loperamide-induced constipation in rats fed high fat diet. FASEB J. 2010, 24, 922.7. [Google Scholar] [CrossRef]
- Yoshinaga, K.; Maruya, R.; Koikeda, T.; Nakano, T. Effects of Undaria pinnatifida (wakame) on the human intestinal environment. Funct. Food Health Dis. 2018, 8, 488–504. [Google Scholar] [CrossRef]
- Chaudhri, O.; Small, C.; Bloom, S. Gastrointestinal hormones regulating appetite. Philos. Trans. R Soc. Lond. B Biol. Sci. 2006, 361, 1187–1209. [Google Scholar] [CrossRef] [PubMed] [Green Version]
- Zeng, Q.; Ou, L.; Wang, W.; Guo, D.Y. Gastrin, Cholecystokinin, signaling, and biological activities in cellular processes. Front Endocrinol. (Lausanne) 2020, 11, 112. [Google Scholar] [CrossRef]
- Lopez, L.C.; Frazier, M.L.; Su, C.J.; Kumar, A.; Saunders, G.F. Mammalian pancreatic preproglucagon contains three glucagon-related peptides. Proc. Natl. Acad. Sci. USA 1983, 80, 5485–5489. [Google Scholar] [CrossRef] [Green Version]
- Kim, J.E.; Park, J.W.; Kang, M.J.; Choi, H.J.; Bae, S.J.; Choi, Y.; Lee, Y.J.; Seo, S.; Hong, J.T.; Hwang, D.Y. Laxative effect of spicatoside A by cholinergic regulation of enteric nerve in loperamide-induced constipation: ICR mice model. Molecules 2019, 24, 896. [Google Scholar] [CrossRef] [Green Version]
- Kim, J.E.; Kang, M.J.; Choi, J.Y.; Park, J.J.; Lee, M.R.; Song, B.R.; Kim, H.R.; Park, J.W.; Choi, H.J.; Bae, S.J.; et al. Regulation of gastrointestinal hormones during laxative activity of gallotannin-enriched extract isolated from Galla Rhois in loperamide-induced constipation of SD rats. Lab. Anim. Res. 2018, 34, 223–231. [Google Scholar] [CrossRef] [PubMed]
- Hirota, C.L.; Mckay, D.M. Cholinergic regulation of epithelial ion transport in the mammalian intestine. Br. J. Pharmacol. 2006, 149, 463–479. [Google Scholar] [CrossRef]
- Kim, J.E.; Go, J.; Sung, J.E.; Lee, H.A.; Yun, W.B.; Hong, J.T.; Hwang, D.Y. Uridine stimulate laxative effect in the loperamide-induced constipation of SD rats through regulation of the mAChRs signaling pathway and mucin secretion. BMC Gastroenterol. 2017, 17, 21. [Google Scholar] [CrossRef] [Green Version]
- Ragan, M.A.; Glombitza, K.W. Handbook of Physiological Methods. Cambridge University Press: Cambridge, UK, 1986; pp. 129–241. [Google Scholar]
- Yoon, N.Y.; Chung, H.Y.; Kim, H.R.; Choi, J.S. Acetyl- and butyryl-cholinesterase inhibitory activities of sterols and phlorotannins from Ecklonia stolonifera. Fisheries Sci. 2008, 74, 200–207. [Google Scholar] [CrossRef]
- Nagayama, K.; Shibata, T.; Fujimoto, K.; Honjo, T.; Nakamura, T. Algicidal effect of phlorotannins from the brown alga Ecklonia kurome on red tide microalgae. Aquaculture 2003, 218, 601–611. [Google Scholar] [CrossRef]
- Lee, H.S.; Jeong, M.S.; Ko, S.C.; Heo, S.Y.; Kang, H.W.; Kim, S.W.; Hwang, C.W.; Lee, K.D.; Oak, C.; Jung, M.J.; et al. Fabrication and biological activity of polycaprolactone/phlorotannin endotracheal tube to prevent tracheal stenosis: An in vitro and in vivo study. J. Biomed. Mater. Res. B Appl. Biomater. 2020, 108, 1046–1056. [Google Scholar] [CrossRef]
- Lee, H.S.; Kim, S.W.; Oak, C.; Kang, H.W.; Oh, J.; Jung, M.J.; Kim, S.B.; Won, J.H.; Lee, K.D. Rabbit model of tracheal stenosis using cylindrical diffuser. Lasers Surg. Med. 2017, 49, 372–379. [Google Scholar] [CrossRef]
- Abbas, S.; Bashir, S.; Khan, A.; Mehmood, M.H.; Gilani, A.H. Gastrointestinal stimulant effect of Urginea indica Kunth. and involvement of muscarinic receptors. Phytother. Res. 2012, 26, 704–708. [Google Scholar] [CrossRef] [PubMed]
- Choi, J.S.; Kim, J.W.; Cho, H.R.; Kim, K.Y.; Lee, J.K.; Sohn, J.H.; Ku, S.K. Laxative effects of fermented rice extract in rats with loperamide-induced constipation. Exp. Ther. Med. 2014, 8, 1847–1854. [Google Scholar] [CrossRef] [PubMed]
- Bae, S.J.; Kim, J.E.; Choi, H.J.; Choi, Y.J.; Lee, S.J.; Gong, J.E.; Seo, S.B.; Yang, S.Y.; An, B.S.; Lee, H.S.; et al. α-Linolenic acid-enriched cold-pressed perilla oil suppress high-fat diet-induced hepatic steatosis through amelioration of the ER stress-mediated autophagy. Molecules 2020, 25, 2662. [Google Scholar] [CrossRef] [PubMed]
- Livak, K.J.; Schmittgen, T.D. Analysis of relative gene expression data using real-time quantitative PCR and the 2(-Delta Delta C(T)) method. Methods 2001, 25, 402–408. [Google Scholar] [CrossRef]
- Choi, Y.J.; Kim, J.E.; Lee, S.J.; Gong, J.E.; Son, H.J.; Hong, J.T.; Hwang, D.Y. Dysbiosis of fecal microbiota from complement 3 knockout mice with constipation phenotypes contributes to development of defecation delay. Front. Physiol. 2021, 12, 650789. [Google Scholar] [CrossRef]
- Chen, S.; Zhou, Y.; Chen, Y.; Gu, J. Fastp: An ultra-fast all-in-one FASTQ preprocessor. Bioinformatics 2018, 34, i884–i890. [Google Scholar] [CrossRef]
- Li, W.; Fu, L.; Niu, B.; Wu, S.; Wooley, J. Ultrafast clustering algorithms for metagenomic sequence analysis. Bioinformatic 2012, 13, 656–668. [Google Scholar] [CrossRef]
- Zhang, Z.; Schwartz, S.; Wagner, L.; Miller, W. A greedy algorithm for aligning DNA sequences. J. Comput. Biol. 2000, 7, 203–214. [Google Scholar] [CrossRef] [PubMed]
- Caporaso, J.G.; Kuczynski, J.; Stombaugh, J.; Bittinger, K.; Bushman, F.D.; Costello, E.K.; Fierer, N.; Pena, A.G.; Goodrich, J.K.; Gordon, J.I.; et al. QIIME allows analysis of high-throughput community sequencing data. Nat. Methods. 2010, 7, 335–336. [Google Scholar] [CrossRef] [PubMed] [Green Version]

Publisher’s Note: MDPI stays neutral with regard to jurisdictional claims in published maps and institutional affiliations. |
© 2021 by the authors. Licensee MDPI, Basel, Switzerland. This article is an open access article distributed under the terms and conditions of the Creative Commons Attribution (CC BY) license (https://creativecommons.org/licenses/by/4.0/).
Share and Cite
Kim, J.-E.; Choi, Y.-J.; Lee, S.-J.; Gong, J.-E.; Jin, Y.-J.; Park, S.-H.; Lee, H.-S.; Choi, Y.-W.; Hong, J.-T.; Hwang, D.-Y. Laxative Effects of Phlorotannins Derived from Ecklonia cava on Loperamide-Induced Constipation in SD Rats. Molecules 2021, 26, 7209. https://doi.org/10.3390/molecules26237209
Kim J-E, Choi Y-J, Lee S-J, Gong J-E, Jin Y-J, Park S-H, Lee H-S, Choi Y-W, Hong J-T, Hwang D-Y. Laxative Effects of Phlorotannins Derived from Ecklonia cava on Loperamide-Induced Constipation in SD Rats. Molecules. 2021; 26(23):7209. https://doi.org/10.3390/molecules26237209
Chicago/Turabian StyleKim, Ji-Eun, Yun-Ju Choi, Su-Jin Lee, Jeong-Eun Gong, You-Jung Jin, So-Hae Park, Hee-Seob Lee, Young-Whan Choi, Jin-Tae Hong, and Dae-Youn Hwang. 2021. "Laxative Effects of Phlorotannins Derived from Ecklonia cava on Loperamide-Induced Constipation in SD Rats" Molecules 26, no. 23: 7209. https://doi.org/10.3390/molecules26237209
APA StyleKim, J.-E., Choi, Y.-J., Lee, S.-J., Gong, J.-E., Jin, Y.-J., Park, S.-H., Lee, H.-S., Choi, Y.-W., Hong, J.-T., & Hwang, D.-Y. (2021). Laxative Effects of Phlorotannins Derived from Ecklonia cava on Loperamide-Induced Constipation in SD Rats. Molecules, 26(23), 7209. https://doi.org/10.3390/molecules26237209

